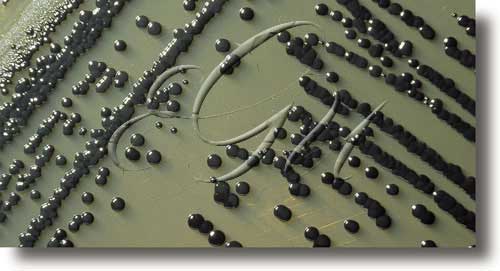

bacteria
(
-
s
f
[MONERA]
Nome co que se designa habitualmente calquera dos representantes da actual clase das bacterias ou esquizomicetos.
Confrontacións: microbio, xerme, bacilo. -
s
f pl
[MONERA]
Clase de microorganismos unicelulares de estrutura protocariótica, xeralmente heterotróficos e con multiplicación por escisiparidade transversa. A maioría das bacterias están formadas por un citoplasma granuloso sen vacuolos e envolto por unha membrana citoplasmática que serve de soporte aos enzimas respiratorios e aos eventuais pigmentos fotosintetizadores. A membrana pode invaxinarse e constituír os mesosomas, e dentro do citoplasma pódense observar inclusións granulosas que corresponden a substancias de reserva. A parede celular, que envolve por fóra a membrana citoplasmática ou celular, é de material peptídico (peptidoglicano) a base de ácido murámico. Nun gran grupo de bacterias a capa de peptidoglicano é grosa, uniforme e densa, e a parede queda tinguida pola tintura de Gram, feito que determina as chamadas bacterias Gram-positivas; as bacterias que non permanecen tinguidas chámanse Gram-negativas. En xeral, as bacterias poden presentar unha forma esférica (cocos) ou cilíndrica (bacilos); os cocos que forman parella chámanse diplococos, os que forman cadeas estreptococos, os que forman agrupacións en forma de acios, estafilococos, e os que se presentan en formas tetraédricas ou cúbicas, sarcinas; os bacilos, se son moi curtos, chámanse cocobacilos; se son afiados polos extremos, fusiformes; se teñen filamentos longos, filamentosos; se son curvos, vibrións; e se teñen forma de tirabuzón, espirilos. Non teñen un verdadeiro núcleo, xa que o material xenético non está separado do plasma por unha membrana. As bacterias, que son haploides, teñen unha reprodución asexual, por escisiparidade ou división lonxitudinal ou transversal. Hai tamén unha transferencia de xenes dunha célula a outra que debe ser considerada unha verdadeira forma de sexualidade. A maioría das bacterias son inmóbiles; as que se moven poden facelo grazas a movementos sinuosos de flexión (espiroquetais), por deslizamento sobre medios sólidos (mixobacteriais) ou mediante flaxelos de estrutura simple. Diversas bacterias presentan tamén pelos ou fimbrias, estruturas inmóbiles que teñen unha función de adherencia da célula a determinadas superficies. Dende o punto de vista do seu metabolismo moitas utilizan o osíxeno como aceptante final de electróns das súas cadeas respiratorias (aerobias), pero outras (anaerobias) utilizan outras substancias, tanto orgánicas (fermentadoras) como inorgánicas. Algunhas utilizan dúas destas formas de obtención de enerxía segundo as características do medio (anaerobias facultativas); outras, a pesar de ser aeróbicas, necesitan baixas presións parciais de osíxeno, son as chamadas microaerófilas. En xeral son heterotróficas (quimioorganotrofos) e só poden utilizar substratos orgánicos, pero algúns grupos poden vivir autotroficamente ben porque dispoñen de pigmentos fotosintetizadores ou porque utilizan enerxía química de determinadas reaccións de oxidorredución (quimiolitotrofos); hai algunhas bacterias que, a pesar de ser fotosintetizadoras, necesitan un substrato orgánico e, polo tanto, son heterotróficas (fotoorganotrofas). Para multiplicarse e realizar as súas funcións metabólicas necesitan un medio acuoso con presenza de ións inorgánicos e de oligoelementos. Algunhas, chamadas termófilas, resisten temperaturas que chegan aos 90°C e crecen ben ata os 50-55°C; para outras (mesófilas) o desenvolvemento óptimo dáse nos 37-44°C se viven no organismo humano, ou arredor dos 30°C se están dispersos no medio; finalmente, as criófilas ou psicrófilas desenvólvense incluso por debaixo dos 0°C. Toleran cambios de pH de 3 e 4 unidades. Segundo a especie poden crecer desde un pH inferior a 1 ata un pH superior a 9. Cando as condicións non son favorables, moitas adquiren formas de resistencia ou esporas. Moitas bacterias viven como parasitos sobre outros organismos ou forman parte da poboación normal de diversos órganos de animais ou vexetais superiores; algunhas son patóxenas e poden causar enfermidades noutros organismos, vexetais ou animais, mesmo no home. As vías de penetración nos organismos son sempre os tegumentos, especialmente (nos animais) a mucosa respiratoria, a dixestiva e a pel. Unha vez nos tecidos as bacterias poden diseminarse a través deles ou penetrar nos vasos linfáticos ata o torrente circulatorio que as distribuirá por todo o organismo ata chegar aos tecidos máis adecuados para a súa multiplicación. O poder patóxeno das bacterias depende da súa capacidade de invasión, favorecida por algúns enzimas (hialuronidasa ou estreptocinasa), da súa resistencia aos mecanismos defensivos do organismo e das toxinas elaboradas por estes. A maioría das bacterias viven libres no po atmosférico, no solo, no mar e nas augas continentais; algunha destas pode tamén volverse patóxena ao entrar accidentalmente nun organismo (Clostridium tetani, C. botulinum, etc). Calculouse que cada persoa é portadora de 10 14 bacterias e a poboación humana total excreta polo recto de 10 22 a 10 23 cada día. Hai máis de tres mil especies diferentes e parece seguro que os fósiles máis primitivos que se coñecen corresponden a bacterias, atopados en rochas de 3 x 10 9 anos de antigüidade. As bacterias teñen un papel importantísimo na regulación dos ciclos de materia e enerxía. As chamadas bacterias nitrificantes, por exemplo, fan posible o paso de amoníaco a nitrito (Nitrosomonas) e de nitrito a nitrato (Nitrobacter). A súa capacidade de transformación de determinados substratos e de síntese de distintas substancias útiles para o home, convertíronas na base de diversas industrias, por exemplo na elaboración de vinagre, de queixos, de iogures, etc. Tamén teñen interese polo seu papel na alteración de alimentos e na degradación dos produtos máis diversos (biodegradación). A posición sistemática das bacterias dentro das clasificacións dos organismos foi moi discutida. A última tendencia é a de considerar todos os procariotas (esquizoficias, bacterias, rickettsias, virus) un reino á parte, no que as bacterias ou esquizomicetos formarían unha clase. Clasifícanse as bacterias segundo as súas características metabólicas e, secundariamente, pola súa morfoloxía.